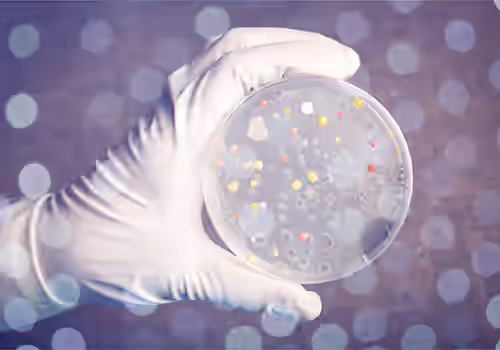

Get Fast Answers to a Serious Problem
Anthrax isn’t an issue you want to take lightly. Without proper diagnosis and treatment, an Anthrax infection can be fatal in up to 90% of cases. Pace® microbiology laboratories are equipped with advanced equipment and staffed by experts who can help you find answers—fast! Our team has extensive experience in detecting and analyzing potentially dangerous pathogens, including Bacillus anthracis, the bacterium responsible for Anthrax.
CONTACT PACE® ABOUT
ANTHRAX TESTING SERVICES
Emergency Anthrax Investigation Services
If you need emergency testing services for an open Anthrax investigation, please contact the Pace® Emergency Response Team at 877.859.7778. For all other testing needs, contact Pace® for more information or to request a quote.
What Is Anthrax?
Anthrax is a serious infectious disease caused by the bacterium Bacillus anthracis. It primarily affects livestock but can also infect humans through contact with contaminated animals, animal products, or spores present in soil. The disease can present in several forms—cutaneous, inhalational, gastrointestinal, and injection anthrax—each varying in severity and mode of transmission. Anthrax is known for its ability to form durable spores that can survive in harsh environmental conditions for years, making it a public health concern both naturally and as a potential bioterrorism agent.
Pace® Test Method for Anthrax Investigations
The primary method for detecting Bacillus anthracis is quantitative polymerase chain reaction (qPCR), a molecular technique that amplifies specific DNA sequences, making it possible to quickly detect even small amounts of Bacillus anthracis genetic material in a sample. By targeting unique genetic markers, qPCR can quickly and accurately identify the presence of the bacterium.

Anthrax FAQs
Anthrax scares don’t happen every day, so when they do, it’s not uncommon to have questions. Please reach out to us if you have additional questions or an immediate concern you’d like to discuss.
What Disease Does Anthrax Cause?
Although the bacterium Bacillus anthracis is often referred to as Anthrax, the name of the disease is Anthrax.
How Are Anthrax Samples Collected?
Surface sampling for Anthrax contamination typically involves the use of swabs or wipes to collect material from areas suspected of harboring Bacillus anthracis spores. Investigators use sterile swabs—often moistened with a suitable solution—or pre-moistened wipes to thoroughly rub over the target surfaces, ensuring that any spores present are effectively transferred onto the collection device.
What Precautions Need to Be Taken When Collecting a Sample for Anthrax Analysis?
In our experience, most Anthrax scares tend to be false alarms; however, it is far better to be safe than sorry. Bacillus anthracis is classified as a Biosafety Level 3 (BSL-3) agent, which means enhanced containment and Personal Protective Equipment (PPE) protocols are required. Refer to CDC Guidelines for details.
How Do I Ship a Potential Anthrax Sample to The Lab?
When collecting samples, use sterile, leak-proof containers to prevent contamination and the spread of a potentially dangerous pathogen. Label samples clearly with all required information (sample type, collection date, suspected source, etc.). Environmental samples (surface swabs) can be kept at room temperature, but refrigeration is preferred. Next-day delivery is recommended for the best results. If samples need to be stored for any reason, keep them cool, but do NOT freeze.
How Long Does Anthrax Testing Take?
Once a sample is received, qPCR testing can typically be completed within 48 hours if the lab is notified in advance. If bioterrorism is suspected or there is a potential for further spread, we recommend working through the Pace® Emergency Response Team.
Should I Use an Anthrax Lab Near Me for Faster Results?
Anthrax analysis requires specialized techniques and laboratory technicians trained to perform the analysis safely and accurately. Not many commercial laboratories specialize in Anthrax analysis, so you may be better off overnighting your samples to a lab with the appropriate equipment and expertise. Our team can help you find the Pace® lab with the capacity and experience to provide fast results.